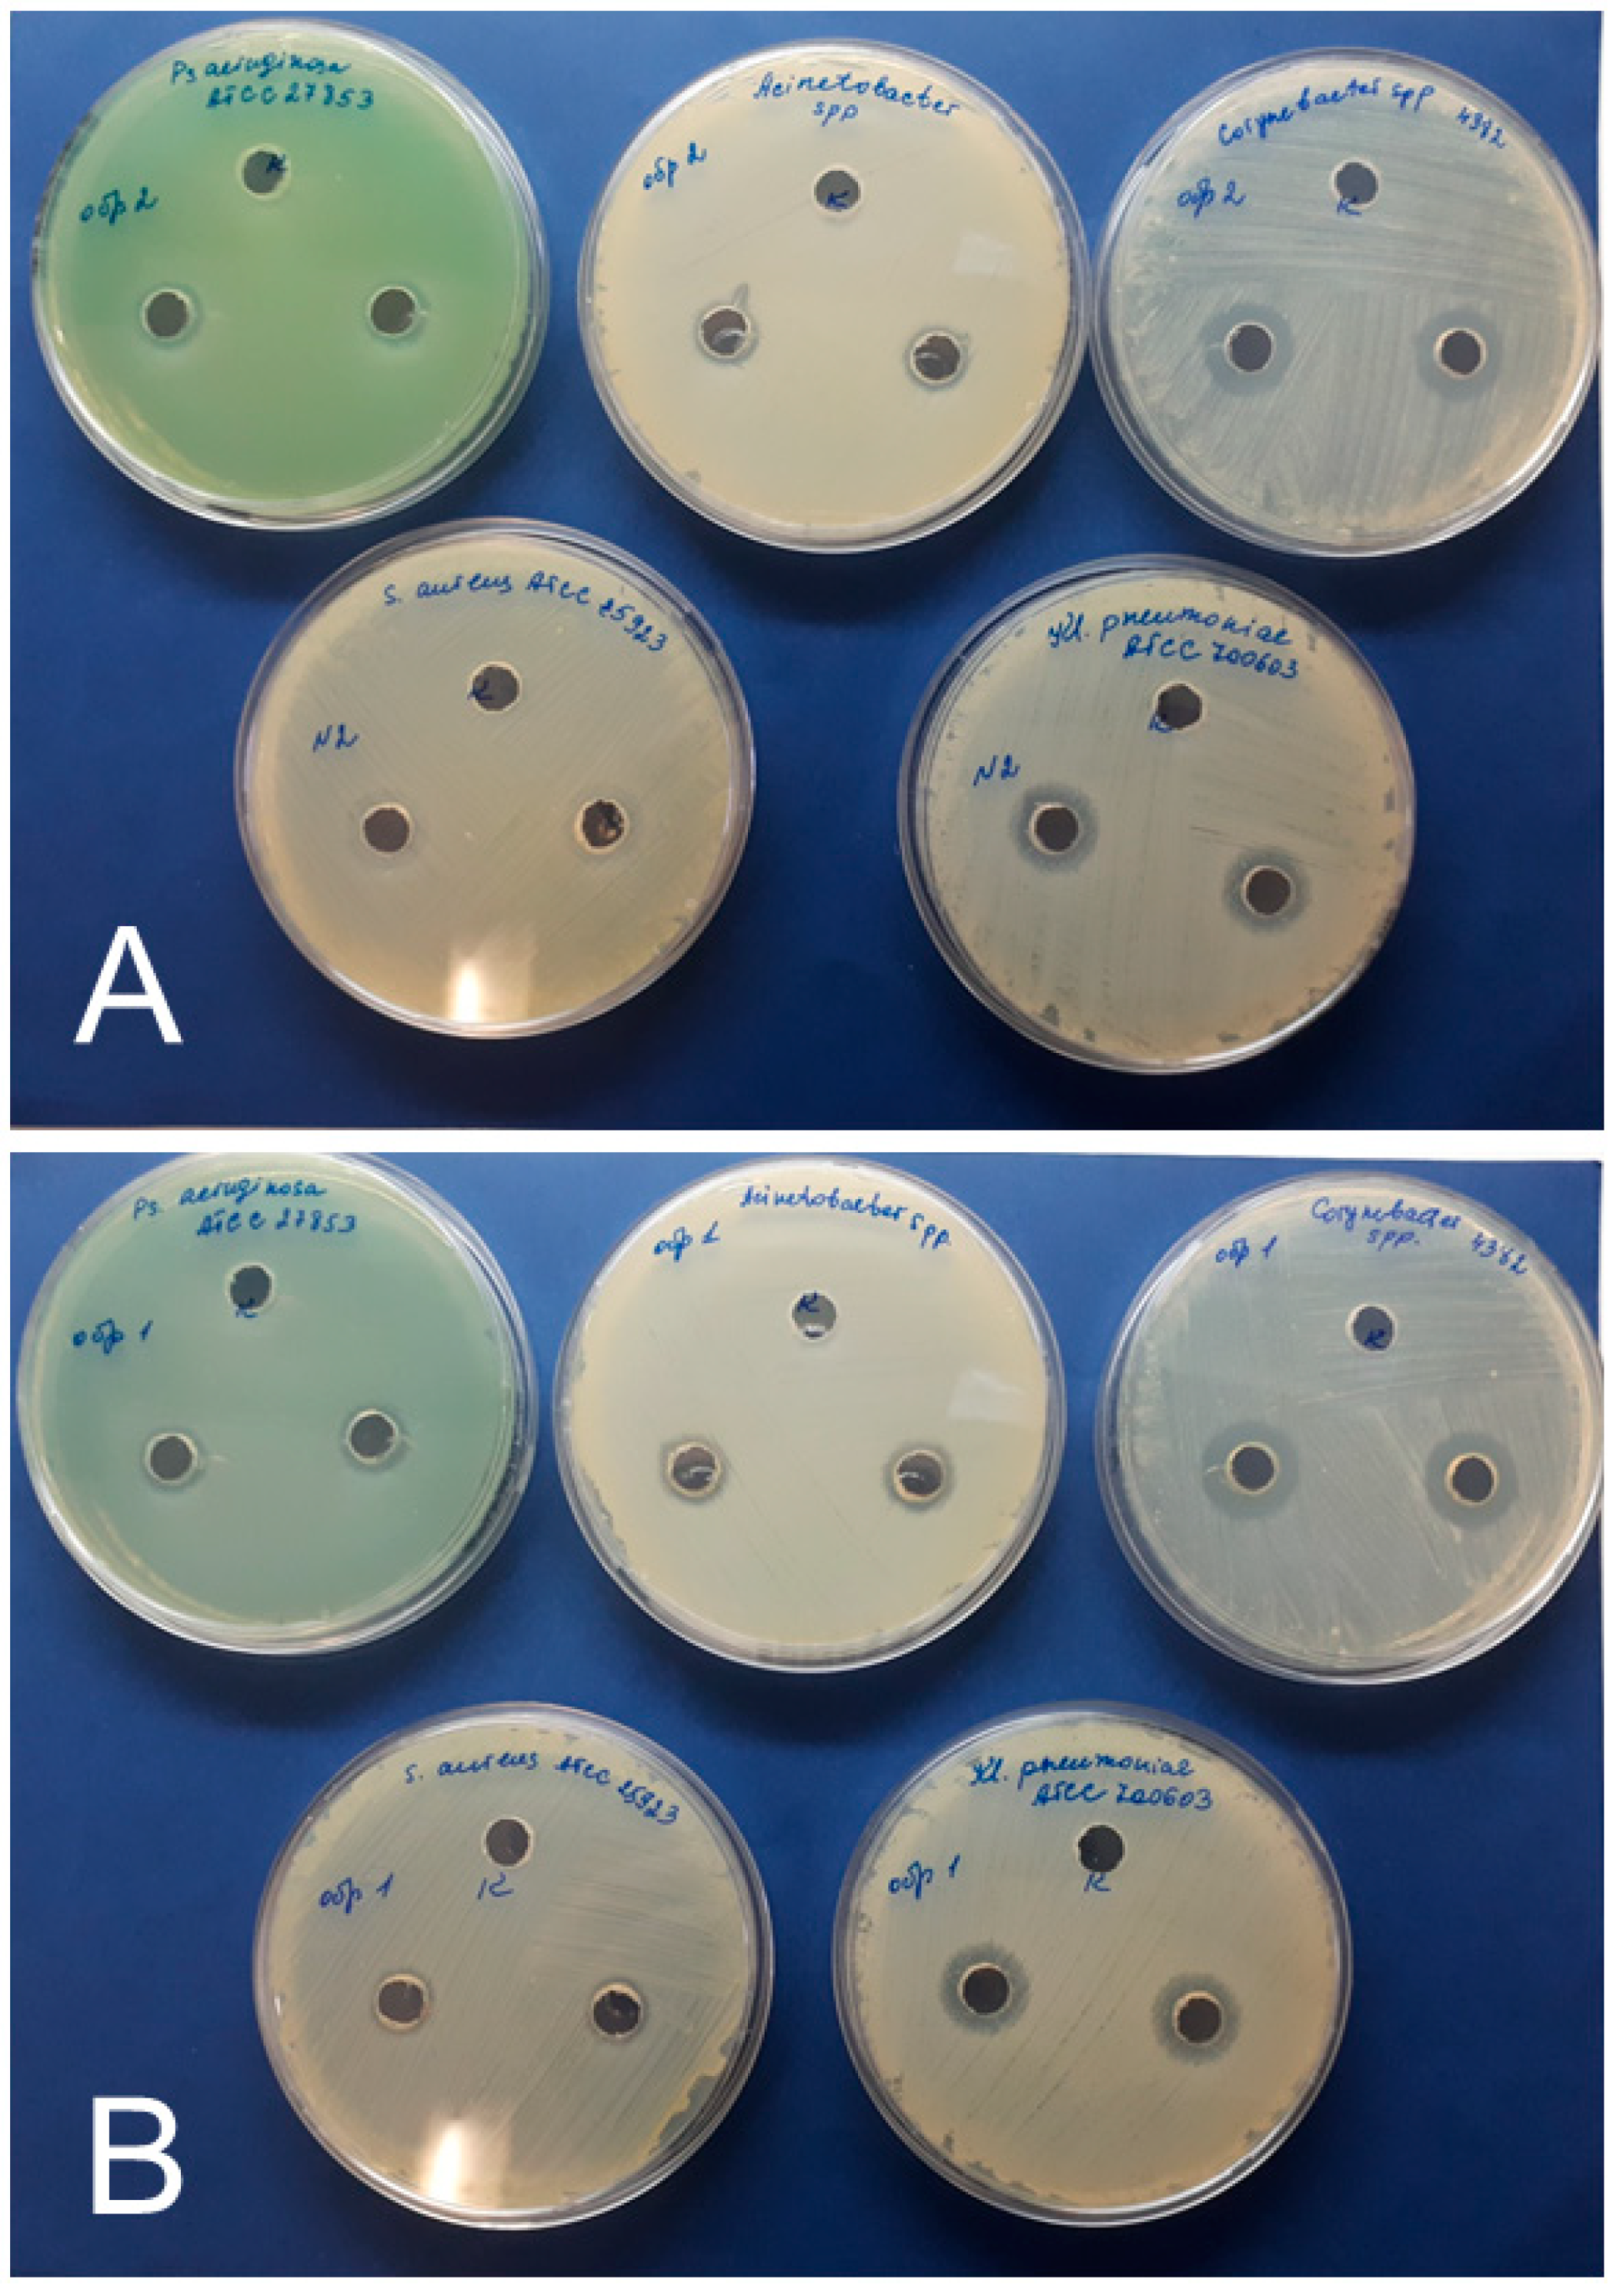
Nanomaterials 11 01484 g007 Nanomaterials 11 01484 g007

Hemolytic Activity, Cytotoxicity, and Antimicrobial Effects of Human Albumin- and Polysorbate-80-Coated Silver Nanoparticles
Abstract
1. Introduction
2. Materials and Methods
2.1. Materials and Reagents
2.2. Preparation of AgNPs
2.3. Modification of Silver Nanoparticles
2.4. Characterization of AgNPs
2.5. Hemolytic Activity of AgNPs
2.6. Cytotoxic Properties of AgNPs
2.7. Antibacterial Assay
2.8. Statistical Analysis
3. Results
3.1. Physicochemical Properties of AgNPs
3.2. Hemolytic Activity of AgNPs Preparations
3.3. Cytotoxicity of AgNPs Preparations
3.4. Antimicrobial Effects of AgNPs
4. Discussion
5. Conclusions
Author Contributions
Funding
Institutional Review Board Statement
Informed Consent Statement
Conflicts of Interest
References
- Rodríguez-Núñez, O.; Agüero, D.L.; Morata, L.; Puerta-Alcalde, P.; Cardozo, C.; Rico, V.; Pitart, C.; Marco, F.; Balibrea, J.M.; Garcia-Vidal, C.; et al. Antibiotic-resistant microorganisms in patients with bloodstream infection of intraabdominal origin: Risk factors and impact on mortality. Infection 2021, 1–10. [Google Scholar] [CrossRef]
- Theuretzbacher, U.; Bush, K.; Harbarth, S.; Paul, M.; Rex, J.H.; Tacconelli, E.; Thwaites, G.E. Critical analysis of antibacterial agents in clinical development. Nat. Rev. Genet. 2020, 18, 286–298. [Google Scholar] [CrossRef] [PubMed]
- Tanwar, J.; Das, S.; Fatima, Z.; Hameed, S. Multidrug Resistance: An Emerging Crisis. Interdiscip. Perspect. Infect. Dis. 2014, 12. [Google Scholar] [CrossRef]
- Abadi, A.T.B.; Rizvanov, A.A.; Haertlé, T.; Blatt, N.L. World Health Organization Report: Current Crisis of Antibiotic Resistance. BioNanoScience 2019, 9, 778–788. [Google Scholar] [CrossRef]
- Vrancianu, C.O.; Gheorghe, I.; Dobre, E.-G.; Barbu, I.C.; Cristian, R.E.; Popa, M.; Lee, S.H.; Limban, C.; Vlad, I.M.; Chifiriuc, M.C. Emerging Strategies to Combat β-Lactamase Producing ESKAPE Pathogens. Int. J. Mol. Sci. 2020, 21, 8527. [Google Scholar] [CrossRef] [PubMed]
- Gómez-Núñez, M.F.; Castillo-López, M.; Sevilla-Castillo, F.; Roque-Reyes, O.J.; Romero-Lechuga, F.; Medina-Santos, D.I.; Martínez-Daniel, R.; Peón, A.N. Nanoparticle-Based Devices in the Control of Antibiotic Resistant Bacteria. Front. Microbiol. 2020, 11. [Google Scholar] [CrossRef] [PubMed]
- Li, W.-R.; Sun, T.-L.; Zhou, S.-L.; Ma, Y.-K.; Shi, Q.-S.; Xie, X.-B.; Huang, X.-M. A comparative analysis of antibacterial activity, dynamics, and effects of silver ions and silver nanoparticles against four bacterial strains. Int. Biodeterior. Biodegrad. 2017, 123, 304–310. [Google Scholar] [CrossRef]
- Burdușel, A.-C.; Gherasim, O.; Grumezescu, A.M.; Mogoantă, L.; Ficai, A.; Andronescu, E. Biomedical Applications of Silver Nanoparticles: An Up-to-Date Overview. Nanomaterials 2018, 8, 681. [Google Scholar] [CrossRef]
- El Mahdy, M.M.; Eldin, T.A.S.; Aly, H.S.; Mohammed, F.F.; Shaalan, M.I. Evaluation of hepatotoxic and genotoxic potential of silver nanoparticles in albino rats. Exp. Toxicol. Pathol. 2015, 67, 21–29. [Google Scholar] [CrossRef]
- Pinzaru, I.; Coricovac, D.; Dehelean, C.; Moacă, E.-A.; Mioc, M.; Baderca, F.; Sizemore, I.; Brittle, S.; Marti, D.; Calina, C.D.; et al. Stable PEG-coated silver nanoparticles—A comprehensive toxicological profile. Food Chem. Toxicol. 2018, 111, 546–556. [Google Scholar] [CrossRef]
- Vuković, B.; Milić, M.; Dobrošević, B.; Milić, M.; Ilić, K.; Pavičić, I.; Šerić, V.; Vrček, I.V. Surface Stabilization Affects Toxicity of Silver Nanoparticles in Human Peripheral Blood Mononuclear Cells. Nanomaterials 2020, 10, 1390. [Google Scholar] [CrossRef] [PubMed]
- Liu, X.; Shan, K.; Shao, X.; Shi, X.; He, Y.; Liu, Z.; Jacob, J.A.; Deng, L. Nanotoxic Effects of Silver Nanoparticles on Normal HEK-293 Cells in Comparison to Cancerous HeLa Cell Line. Int. J. Nanomed. 2021, 16, 753–761. [Google Scholar] [CrossRef]
- Espinosa-Cristóbal, L.F.; Martínez-Castañón, G.A.; Loyola-Rodríguez, J.P.; Niño-Martínez, N.; Ruiz, F.; Zavala-Alonso, N.V.; Lara, R.H.; Reyes-López, S.Y. Bovine Serum Albumin and Chitosan Coated Silver Nanoparticles and Its Antimicrobial Activity against Oral and Nonoral Bacteria. J. Nanomater. 2015, 2015, 1–9. [Google Scholar] [CrossRef]
- Tiwari, A.K.; Gupta, M.K.; Pandey, G.; Narayan, R.J.; Pandey, P.C. Molecular weight of polyethylenimine-dependent transfusion and selective antimicrobial activity of functional silver nanoparticles. J. Mater. Res. 2020, 35, 2405–2415. [Google Scholar] [CrossRef] [PubMed]
- Niyonshuti, I.I.; Krishnamurthi, V.R.; Okyere, D.; Song, L.; Benamara, M.; Tong, X.; Wang, Y.; Chen, J. Polydopamine Surface Coating Synergizes the Antimicrobial Activity of Silver Nanoparticles. ACS Appl. Mater. Interfaces 2020, 12. [Google Scholar] [CrossRef]
- Izak-Nau, E.; Huk, A.; Reidy, B.; Uggerud, H.; Vadset, M.; Eiden, S.; Voetz, M.; Himly, M.; Duschl, A.; Dusinska, M.; et al. Impact of storage conditions and storage time on silver nanoparticles’ physicochemical properties and implications for their biological effects. RSC Adv. 2015, 5, 84172–84185. [Google Scholar] [CrossRef]
- Gupta, K.; Chhibber, S. Biofunctionalization of Silver Nanoparticles with Lactonase Leads to Altered Antimicrobial and Cytotoxic Properties. Front. Mol. Biosci. 2019, 6, 63. [Google Scholar] [CrossRef] [PubMed]
- Lehman, J.W. The Student’s Lab Companion: Laboratory Techniques for Organic Chemistry, 2nd ed.; Prentice Hall: Hoboken, NJ, USA, 2008; pp. 156–157. ISBN 9780131593817. [Google Scholar]
- Yücel, D.; Dalva, K. Effect of In Vitro Hemolysis on 25 Common Biochemical Tests. Clin. Chem. 1992, 38, 575–577. [Google Scholar] [CrossRef] [PubMed]
- Martinez-Castanon, G.-A.; Nino, N.; Martinez-Gutierrez, F.; Martinez, J.R.; Ruiz, F. Synthesis and antibacterial activity of silver nanoparticles with different sizes. J. Nanoparticle Res. 2008, 10, 1343–1348. [Google Scholar] [CrossRef]
- Kudryavtsev, I.V.; Golovkin, A.S.; Zurochka, A.V.; Khaydukov, S.V. Modern methods and approaches to the study of apoptosis in experimental biology. Med. Immunol. 2012, 14, 461–482. [Google Scholar] [CrossRef][Green Version]
- Panina, A.; Tverdokhlebov, S.I.; Golovkin, A.S.; Mishenin, A.I. Approaches to Biomaterials Testing according to Modern Biocompatibility Paradigm. Transl. Med. 2017, 4, 29–40. [Google Scholar]
- Brown, D.F.; Kothari, D. Comparison of antibiotic discs from different sources. J. Clin. Pathol. 1975, 28, 779–783. [Google Scholar] [CrossRef] [PubMed]
- Khatami, M.; Noor, F.G.; Ahmadi, S.; Aflatoonian, M. Biosynthesis of Ag nanoparticles using Salicornia bigelovii and its antibacterial activity. Electron. Physician 2018, 10, 6733–6740. [Google Scholar] [CrossRef]
- Küünal, S.; Rauwel, P.; Rauwel, E. Plant extract mediated synthesis of nanoparticles. In Emerging Applications of Nanoparticles and Architecture Nanostructures; Elsevier: Amsterdam, The Netherlands, 2018; pp. 411–446. [Google Scholar] [CrossRef]
- Rajan, R.; Chandran, K.; Harper, S.L.; Yun, S.-I.; Kalaichelvan, P.T. Plant extract synthesized silver nanoparticles: An ongoing source of novel biocompatible materials. Ind. Crop. Prod. 2015, 70, 356–373. [Google Scholar] [CrossRef]
- Küünal, S.; Visnapuu, M.; Volubujeva, O.; Rosario, M.S.; Rauwel, P.; Rauwel, E. Optimisation of plant mediated synthesis of silver nanoparticles by common weed Plantago major and their antimicrobial properties. IOP Conf. Ser. Mater. Sci. Eng. 2019, 613, 012003. [Google Scholar] [CrossRef]
- Nakamura, S.; Sato, M.; Sato, Y.; Ando, N.; Takayama, T.; Fujita, M.; Ishihara, M. Synthesis and Application of Silver Nanoparticles (Ag NPs) for the Prevention of Infection in Healthcare Workers. Int. J. Mol. Sci. 2019, 20, 3620. [Google Scholar] [CrossRef]
- Gherasim, O.; Puiu, R.A.; Bîrcă, A.C.; Burdușel, A.-C.; Grumezescu, A.M. An Updated Review on Silver Nanoparticles in Biomedicine. Nanomaterials 2020, 10, 2318. [Google Scholar] [CrossRef] [PubMed]
- Gaikwad, S.; Ingle, A.; Gade, A.; Rai, M.; Falanga, A.; Incoronato, N.; Russo, L.; Galdiero, S.; Galdiero, M. Antiviral activity of mycosynthesized silver nanoparticles against herpes simplex virus and human parainfluenza virus type 3. Int. J. Nanomed. 2013, 8, 4303–4314. [Google Scholar]
- Virkutyte, J.; Varma, R.S. Green synthesis of metal nanoparticles: Biodegradable polymers and enzymes in stabilization and surface functionalization. Chem. Sci. 2011, 2, 837–846. [Google Scholar] [CrossRef]
- Kasim, A.S.M.; Bin Ariff, A.; Mohamad, R.; Wong, F.W.F. Interrelations of Synthesis Method, Polyethylene Glycol Coating, Physico-Chemical Characteristics, and Antimicrobial Activity of Silver Nanoparticles. Nanomaterials 2020, 10, 2475. [Google Scholar] [CrossRef] [PubMed]
- Pareek, V.; Devineau, S.; Sivasankaran, S.K.; Bhargava, A.; Panwar, J.; Srikumar, S.; Fanning, S. Silver Nanoparticles Induce a Triclosan-Like Antibacterial Action Mechanism in Multi-Drug Resistant Klebsiella pneumoniae. Front. Microbiol. 2021, 12. [Google Scholar] [CrossRef]
- Chang, X.; Wang, X.; Li, J.; Shang, M.; Niu, S.; Zhang, W.; Li, Y.; Sun, Z.; Gan, J.; Li, W.; et al. Silver nanoparticles induced cytotoxicity in HT22 cells through autophagy and apoptosis via PI3K/AKT/mTOR signaling pathway. Ecotoxicol. Environ. Saf. 2021, 208, 111696. [Google Scholar] [CrossRef] [PubMed]
- De Brito, J.L.M.; De Lima, V.N.; Ansa, D.O.; Moya, S.E.; Morais, P.C.; De Azevedo, R.B.; Lucci, C.M. Acute reproductive toxicology after intratesticular injection of silver nanoparticles (AgNPs) in Wistar rats. Nanotoxicology 2020, 14, 893–907. [Google Scholar] [CrossRef] [PubMed]
- Bekhit, M.; Abu El-Naga, M.N.; Sokary, R.; Fahim, R.A.; El-Sawy, N.M. Radiation-induced synthesis of tween 80 stabilized silver nanoparticles for antibacterial applications. J. Environ. Sci. Health Part A 2020, 55, 1210–1217. [Google Scholar] [CrossRef]
- Scolari, I.R.; Volpini, X.; Fanani, M.L.; De La Cruz-Thea, B.; Natali, L.; Musri, M.M.; Granero, G.E. Exploring the Toxicity, Lung Distribution, and Cellular Uptake of Rifampicin and Ascorbic Acid-Loaded Alginate Nanoparticles as Therapeutic Treatment of Lung Intracellular Infections. Mol. Pharm. 2021, 18, 807–821. [Google Scholar] [CrossRef]
- Xue, Y.; Ding, J.; Liu, Y.; Pan, Y.; Zhao, P.; Ren, Z.; Xu, J.; Ye, L.; Xu, Y. Preparation and Evaluation of Recombinant Human Erythropoietin Loaded Tween 80-Albumin Nanoparticle for Traumatic Brain Injury Treatment. Int. J. Nanomed. 2020, 15, 8495–8506. [Google Scholar] [CrossRef]
- Hennenfent, K.L.; Govindan, R. Novel formulations of taxanes: A review. Old wine in a new bottle? Ann. Oncol. 2006, 17, 735–749. [Google Scholar] [CrossRef]
- Singh, A.; Thakur, S.; Singh, H.; Singh, H.; Kaur, S.; Kaur, S.; Dudi, R.; Mondhe, D.M.; Jain, S.K. Novel Vitamin E TPGS based docetaxel nanovesicle formulation for its safe and effective parenteral delivery: Toxicological, pharmacokinetic and pharmacodynamic evaluation. J. Liposome Res. 2020, 1–16. [Google Scholar] [CrossRef]
- De Oliveira, D.M.P.; Forde, B.M.; Kidd, T.J.; Harris, P.N.A.; Schembri, M.A.; Beatson, S.A.; Paterson, D.L.; Walker, M.J. Antimicrobial Resistance in ESKAPE Pathogens. Clin. Microbiol. Rev. 2020, 33. [Google Scholar] [CrossRef] [PubMed]
- Jnana, A.; Muthuraman, V.; Varghese, V.K.; Chakrabarty, S.; Murali, T.S.; Ramachandra, L.; Shenoy, K.R.; Rodrigues, G.S.; Prasad, S.S.; Dendukuri, D.; et al. Microbial Community Distribution and Core Microbiome in Successive Wound Grades of Individuals with Diabetic Foot Ulcers. Appl. Environ. Microbiol. 2020, 86. [Google Scholar] [CrossRef] [PubMed]
- Adeyemo, A.T.; Kolawole, B.; Rotimi, V.O.; Aboderin, A.O. Multicentre study of the burden of multidrug-resistant bacteria in the aetiology of infected diabetic foot ulcers. Afr. J. Lab. Med. 2021, 10, 1261. [Google Scholar] [CrossRef] [PubMed]

| Sample | Hemolysis Coefficient, % | |
|---|---|---|
| Blood of Donor 1 | Blood of Donor 2 | |
| 1 h | ||
| NC | 0 | 0 |
| PC | 100 | 100 |
| AgNPs–SS | 0.156 | 0.114 |
| AgNPs–Alb | 0.678 | 0.743 |
| AgNPs–Tween | 1.199 | 0.828 |
| 2 h | ||
| NC | 0 | 0 |
| PC | 100 | 100 |
| AgNPs–SS | 0.149 | 0.257 |
| AgNPs–Alb | 0.572 | 0.720 |
| AgNPs–Tween | 1.292 | 1.079 |
| 24 h | ||
| NC | 0 | 0 |
| PC | 100 | 100 |
| AgNPs–SS | 0.049 | 0.364 |
| AgNPs–Alb | 0.389 | 0.850 |
| AgNPs–Tween | 27.988 | 36.465 |
| Sample | Mean |
|---|---|
| Control group (nutrient medium for MSC) | 1714 ± 546 |
| Phosphate buffered saline 10 μL | 1656 ± 140 |
| Phosphate buffered saline 100 μL | 1507 ± 269 |
| AgNPs–SS 10 μL | 1499 ± 278 |
| AgNPs–SS 100 μL | 1192 ± 276 * |
| AgNPs–Alb 10 μL | 1508 ± 410 |
| AgNPs–Alb 100 μL | 1190 ± 410 * |
| AgNPs–Tween 10 μL | 1194 ± 176 * |
| AgNPs–Tween 100 μL | 870 ± 311 * |
| AgNPs Preparation and Dose | Living Cells | Early Apoptosis | Necrosis/Late Apoptosis |
|---|---|---|---|
| Control | 87.5 ± 3.2 | 3.3 ± 0.6 | 7.2 ± 2.6 |
| PBS 10 µL | 90.3 ± 1.3 | 4.7 ± 0.6 | 4.2 ± 1.1 |
| PBS 100 µL | 89.7 ± 1.7 | 4.4 ± 0.8 | 5.2 ± 0.5 |
| AgNPs–SS 10 µL | 68.9 ± 4.2 * ^ | 25.7 ± 3.2 * ^ | 5.3 ± 0.3 |
| AgNPs–SS 100 µL | 75.3 ± 5.0 * ^ | 17.2 ± 3.1 * ^ | 7.1 ± 0.5 |
| AgNPs–Alb 10 µL | 86.7 ± 5.3 | 9.5 ± 3.3 ** | 3.5 ± 0.5 |
| AgNPs–Alb 100 µL | 87.7 ± 0.8 | 7.8 ± 0.09 | 4.3 ± 0.6 |
| AgNPs–Tween 10 µL | 87.1 ± 0.5 | 8.9 ± 0.01 ** | 3.6 ± 0.3 |
| AgNPs–Tween 100 µL | — | — | — |
| AgNPs Preparation | Inhibition Zone Diameter (mm) Including the Diameter of the Well (8.0 mm) | ||||
|---|---|---|---|---|---|
| Test Cultures | |||||
| S. aureus | K. pneumoniae | P. aeruginosa | Corynebacterium | Acinetobacter | |
| AgNPs–SS | * Control-0 | Control-0 | Control-0 | Control-0 | Control-0 |
| 10 ± 1 | 16 ± 1 | 12 ± 1 | 16 ± 1 | 12 ± 1 | |
| AgNPs–Alb | Control-0 | Control-0 | Control-0 | Control-0 | Control-0 |
| 10 ± 1 | 14 ± 1 | 12 ± 1 | 18 ± 1 | 12 ± 1 | |
Publisher’s Note: MDPI stays neutral with regard to jurisdictional claims in published maps and institutional affiliations. |
© 2021 by the authors. Licensee MDPI, Basel, Switzerland. This article is an open access article distributed under the terms and conditions of the Creative Commons Attribution (CC BY) license (https://creativecommons.org/licenses/by/4.0/).
Share and Cite
Korolev, D.; Shumilo, M.; Shulmeyster, G.; Krutikov, A.; Golovkin, A.; Mishanin, A.; Gorshkov, A.; Spiridonova, A.; Domorad, A.; Krasichkov, A.; et al. Hemolytic Activity, Cytotoxicity, and Antimicrobial Effects of Human Albumin- and Polysorbate-80-Coated Silver Nanoparticles. Nanomaterials 2021, 11, 1484. https://doi.org/10.3390/nano11061484
Korolev D, Shumilo M, Shulmeyster G, Krutikov A, Golovkin A, Mishanin A, Gorshkov A, Spiridonova A, Domorad A, Krasichkov A, et al. Hemolytic Activity, Cytotoxicity, and Antimicrobial Effects of Human Albumin- and Polysorbate-80-Coated Silver Nanoparticles. Nanomaterials. 2021; 11(6):1484. https://doi.org/10.3390/nano11061484
Chicago/Turabian StyleKorolev, Dmitry, Michael Shumilo, Galina Shulmeyster, Alexander Krutikov, Alexey Golovkin, Alexander Mishanin, Andrew Gorshkov, Anna Spiridonova, Anna Domorad, Alexander Krasichkov, and et al. 2021. "Hemolytic Activity, Cytotoxicity, and Antimicrobial Effects of Human Albumin- and Polysorbate-80-Coated Silver Nanoparticles" Nanomaterials 11, no. 6: 1484. https://doi.org/10.3390/nano11061484
APA StyleKorolev, D., Shumilo, M., Shulmeyster, G., Krutikov, A., Golovkin, A., Mishanin, A., Gorshkov, A., Spiridonova, A., Domorad, A., Krasichkov, A., & Galagudza, M. (2021). Hemolytic Activity, Cytotoxicity, and Antimicrobial Effects of Human Albumin- and Polysorbate-80-Coated Silver Nanoparticles. Nanomaterials, 11(6), 1484. https://doi.org/10.3390/nano11061484






